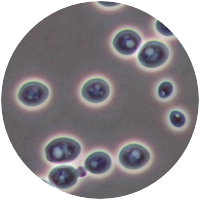

|
50 g
|
149 Kč bez DPH
|
|
500 g
|
1 245 Kč bez DPH
|
|
1000 g
|
|


|
20 g
|
149 Kč bez DPH
|
|
100 g
|
395 Kč bez DPH
|
|
500 g
|
1 495 Kč bez DPH
|

|
20 g
|
329 Kč bez DPH
|
|
100 g
|
769 Kč bez DPH
|
|
500 g
|
2 910 Kč bez DPH
|

|
20 g
|
329 Kč bez DPH
|
|
100 g
|
769 Kč bez DPH
|
|
500 g
|
2 910 Kč bez DPH
|
|
20 g
|
169 Kč bez DPH
|
|
100 g
|
529 Kč bez DPH
|
|
500 g
|
1 995 Kč bez DPH
|











